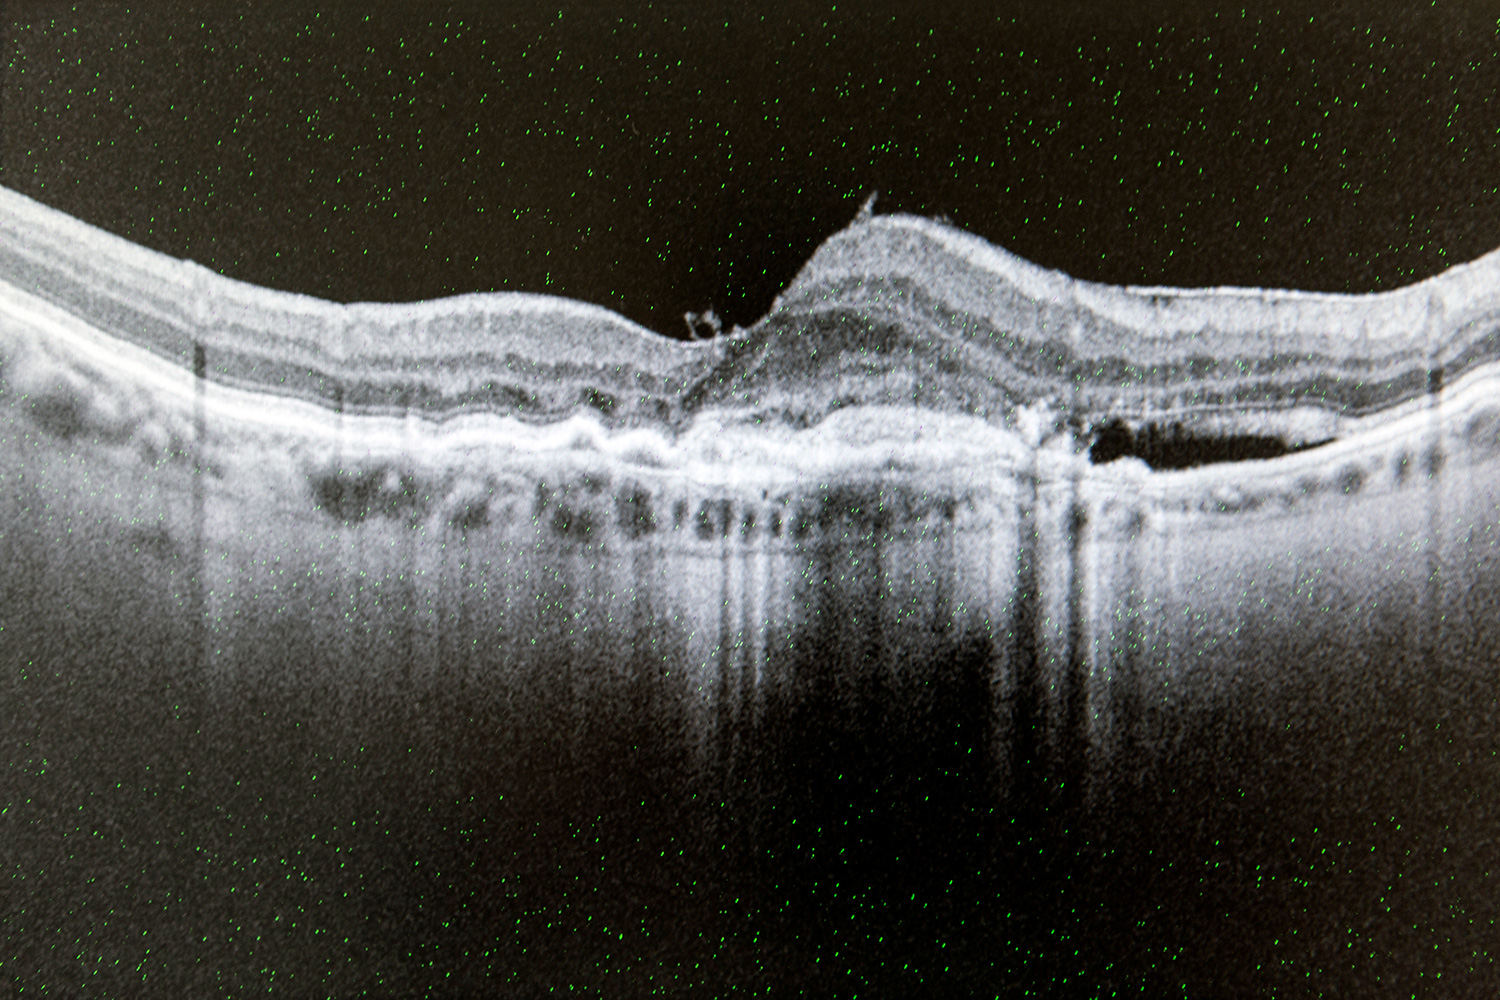

L
Leistungen
A
Ambulante Operationen

Im St. Gertrauden-Krankenhaus führen wir operative Eingriffe durch wie intravitreale Injektionstherapien mit allen zur Verfügung stehenden Medikamenten.
Erkrankungen, die beispielsweise von uns operativ behandelt werden sind: feuchte altersbedingte Makuladegeneration, Makulaödem infolge retinaler Gefäßverschlüsse oder diabetischer Retinopathie, choroidale Neovaskularisationen bei Myopie und alle weiteren zugelassenen Indikationen.
L
Laser

Den sogenannten Argon-Laser setzen wir ein bei: Netzhautrissen, drohender Netzhautablösung, durch Diabetes hervorgerufene Erkrankungen wie diabetischer Retinopathie, bei Gefäßverschlüssen der Netzhaut sowie bei Makulaödem, der Schwellung der Netzhautmitte.
Ein Nd:YAG-Laser kommt bei einer Nachstar-Behandlung zum Einsatz, nachdem Patienten am Grauen Star operiert wurden, sowie bei der Behandlung von Grünem Star (Glaukom).
Die photodynamische Therapie (PDT) wenden wir bei einer Makuladegeneration an. Bei der Therapie werden Medikamente durch kaltes Laserlicht aktiviert.
F
Fundusfotografie

Die Dokumentation und Untersuchung mit der Fundusfotografie bieten Ihnen Sicherheit. Mit einer modernen Funduskamera werden Fotografien des Augenhintergrundes angefertigt, die der Untersuchung und dem Vergleich dienen. Der Vergleich von Aufnahmen, die zu unterschiedlichen Zeitpunkten aufgenommen wurden, ermöglicht uns eine genaue Beobachtung von Krankheitsverläufen.
Wir nutzen eine hochmoderne Digitalkamera der Firma Zeiss.
F
Fluoreszenzangiografie

Bei der Fluoreszenzangiografie injizieren wir einen Farbstoff durch die Armvenen in die Blutbahn, sodass die Blutgefäße der Augen besser sichtbar werden. Danach fertigen wir mit speziellen Filtern Fotografien des Augenhintergrunds an. So können wir insbesondere Durchblutungsstörungen, Gefäßneubildungen oder andere Gefäßveränderungen – unter anderem an der Netzhaut, der Aderhaut oder dem Sehnerv – besser erkennen.
Diese Untersuchung ist vor allem bei der altersbedingten Makuladegeneration sowie Venenthrombosen der Netzhaut hilfreich.
O
OCT
Mit dem OCT-Verfahren machen wir mit Licht unterschiedlicher Wellenlängen feinste Strukturen im Gewebe sichtbar.
Bei einer OCT-Untersuchung tastet ein diagnostischer Laserstrahl die Netzhaut, insbesondere die Makula und den Sehnerv ab. Die Methode gibt uns Einblicke in feinste Strukturen und Veränderungen in der Tiefenausdehnung der Netzhautschichten.
Die Untersuchung ist belastungsfrei.
In unserer Praxis kommt ein hochmodernes Spectral Domain OCT der Fa. Zeiss zum Einsatz.
G
Glaukomdiagnostik

Die Kombination aus Augeninnendruckmessung und Untersuchung des Sehnervenkopfes dient im Wesentlichen der Glaukomvorsorge. In unserer Praxis messen wir zudem berührungsfrei Ihre Hornhautdicke (Pachymetrie) mit einer sogenannten Pentacam und messen und überwachen Ihren Sehnerv mittels HRT beziehungsweise OCT.
S
Sehschule

In unserer Sehschule führt eine erfahrene staatlich geprüfte Orthoptistin Untersuchungen zur Früherkennung von Sehfehlern, Schielen oder etwaigen Augenerkrankungen sowie Brillenbestimmungen durch. Ebenfalls kontrollieren wir in der Sprechstunde Prismenbrillen bei bestimmten Augenfehlern und passen sie an. Und wir überprüfen die Augenstellung sowie das beidäugige Sehen.
Die Sehschule findet dienstagnachmittags und mittwochvormittags statt.
G
Gutachten

- Führerscheingutachten für alle Klassen
- Motor- und Segelbootschein
- Tauglichkeitsuntersuchungen
- Fachärztliche Gutachten für Behörden und Versicherungen